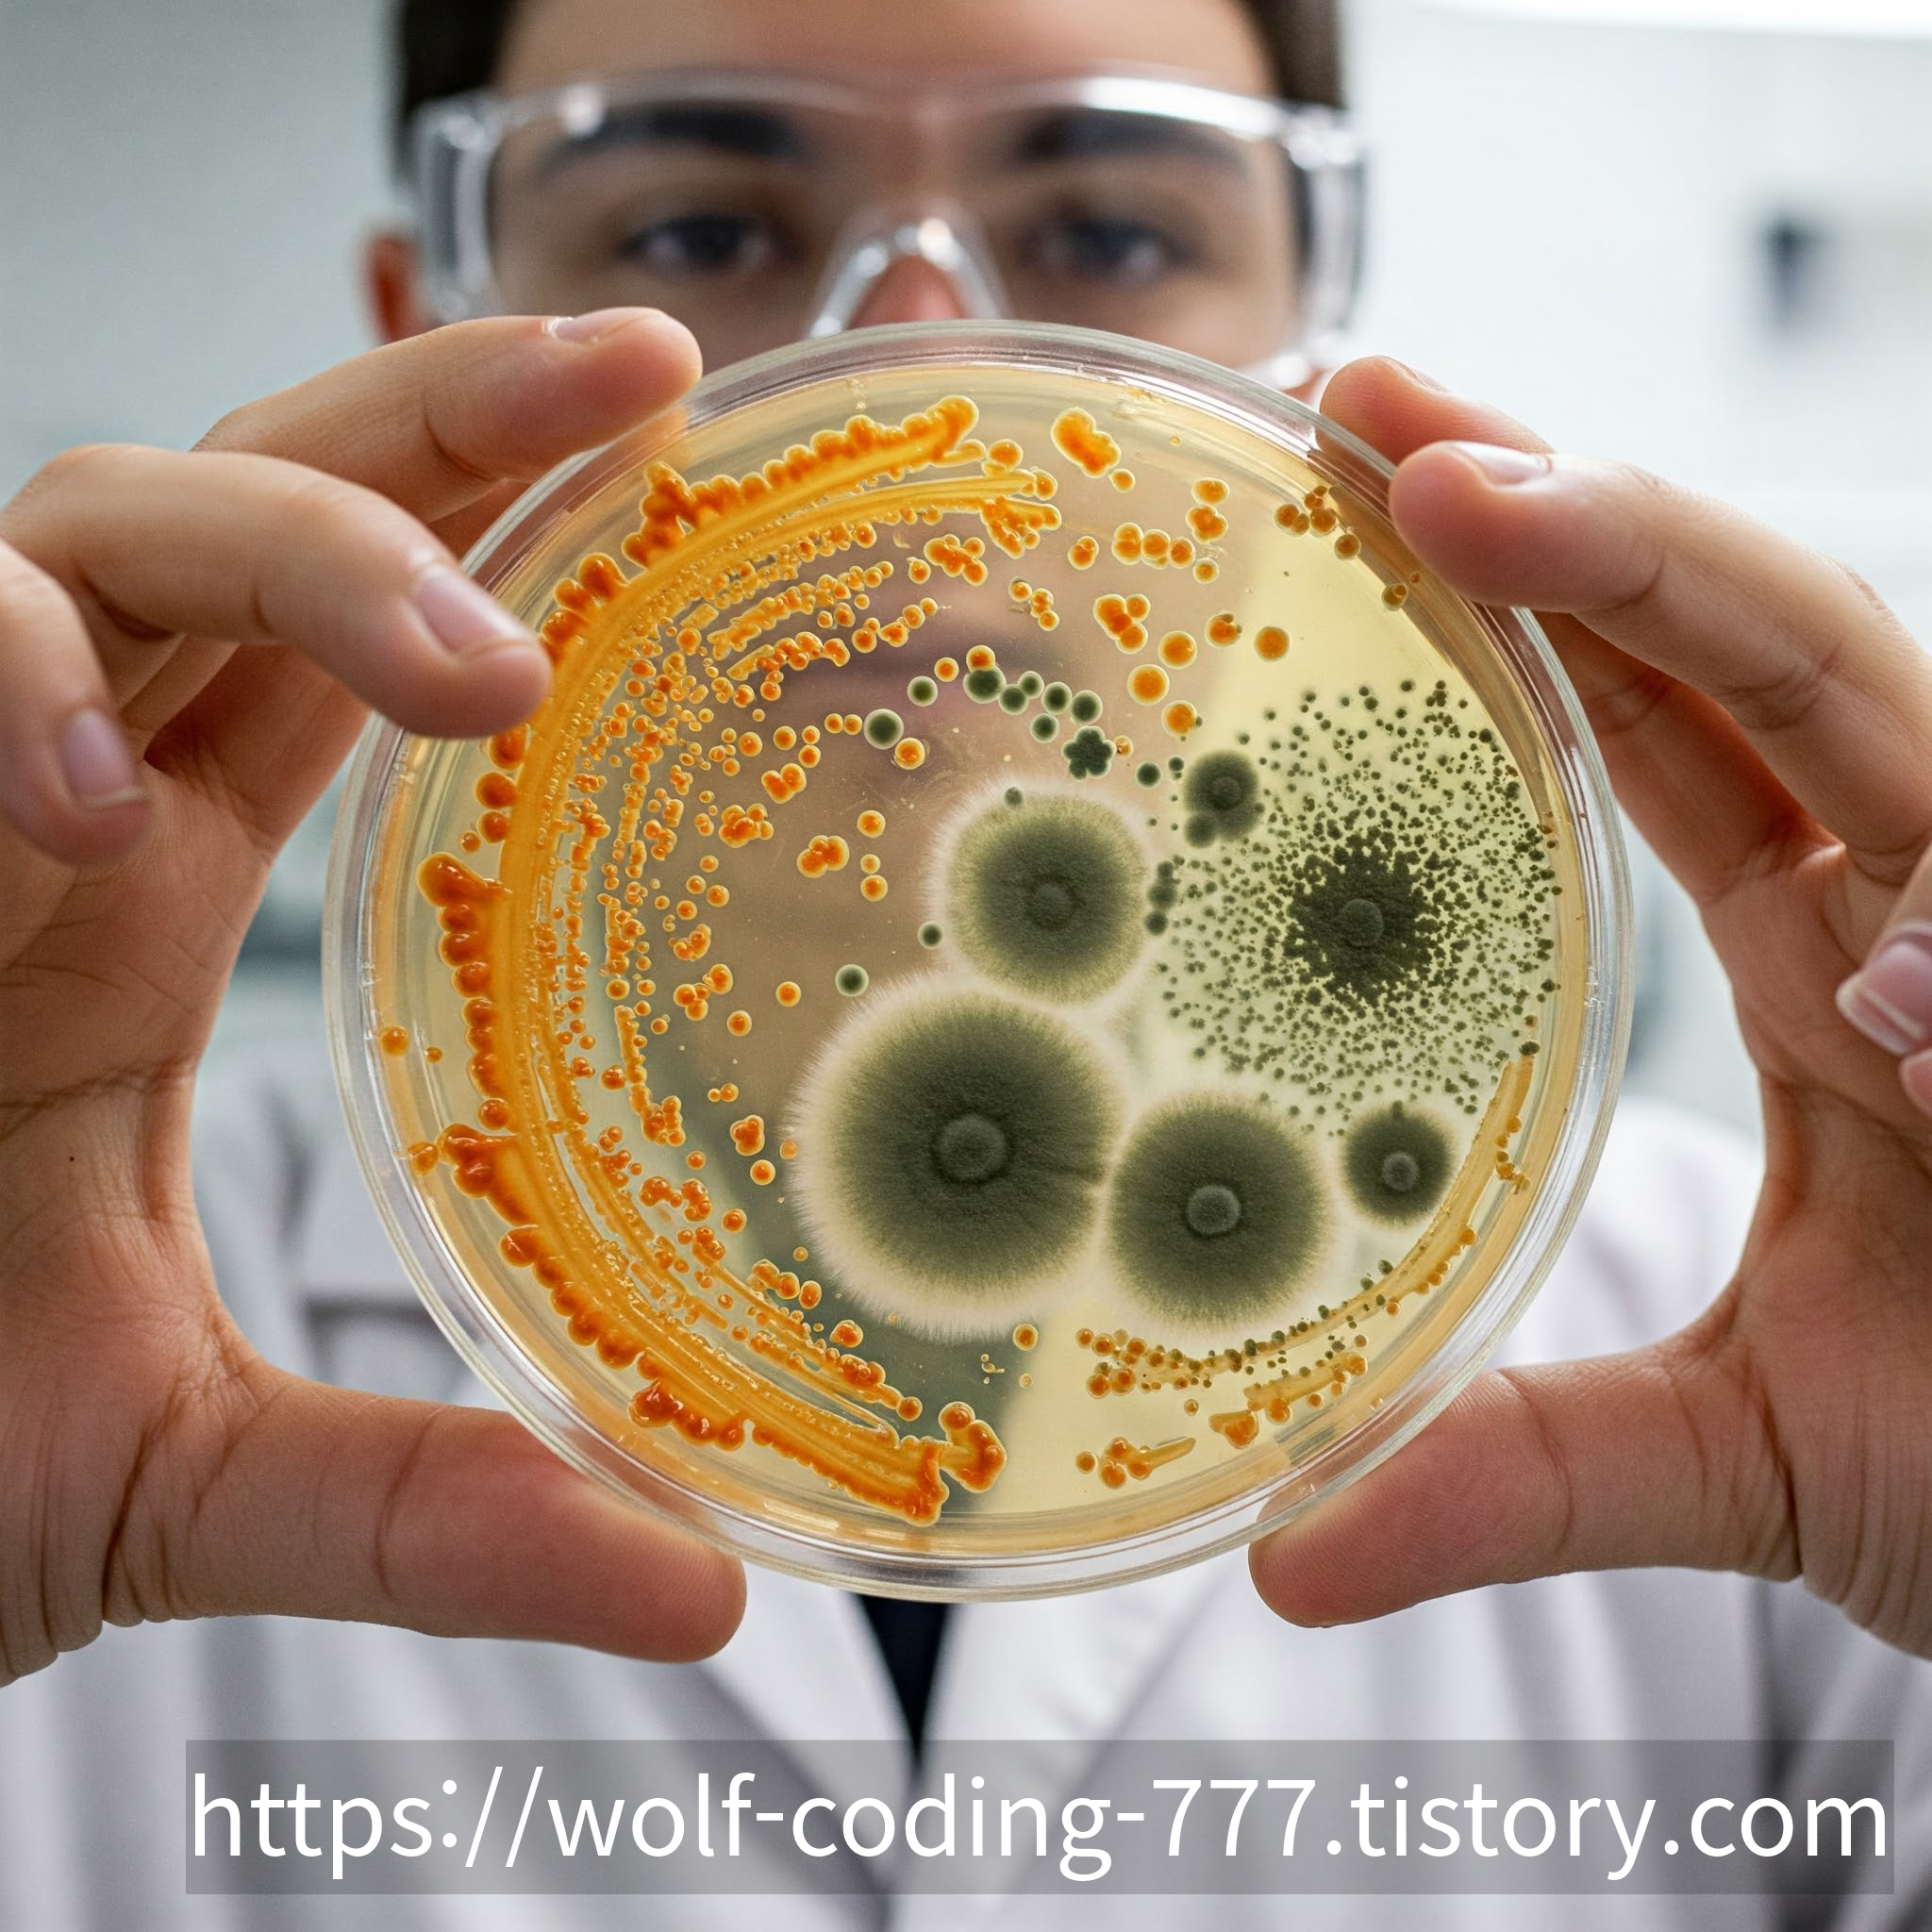

항생제의 역사: 인류를 감염병에서 구원한 혁명적인 발견과 미래 과제
항생제의 역사: 인류를 감염병의 공포에서 구원한 혁명적인 발견
항생제는 세균 감염증 치료에 혁명적인 변화를 가져온 의약품입니다. 20세기 의학 발전의 가장 중요한 업적 중 하나로 꼽히는 항생제의 역사는 우연한 발견과 끈질긴 연구 노력, 그리고 인류를 질병으로부터 구하고자 하는 뜨거운 열정으로 가득 차 있습니다.
고대부터 이어진 감염병 치료의 시도
현대적인 의미의 항생제가 등장하기 훨씬 이전에도 인류는 다양한 방법으로 감염병에 대처해 왔습니다. 고대 이집트, 그리스, 중국 등 여러 문명에서는 곰팡이가 핀 빵이나 특정 식물 추출물을 상처 부위에 사용하여 감염을 치료하려는 시도가 있었습니다. 이러한 민간요법들은 경험적인 지혜를 바탕으로 어느 정도 효과를 보였을 수 있지만, 그 작용 원리는 명확히 밝혀지지 않았습니다.
세균설의 확립과 화학요법의 등장
19세기 후반, 루이 파스퇴르와 로베르트 코흐 등의 과학자들은 세균이 질병의 원인이라는 '세균설'을 확립하면서 감염병 치료에 대한 과학적인 접근이 시작되었습니다. 파울 에를리히는 특정 염료가 세균 세포를 선택적으로 염색시키는 것을 발견하고, 세균에만 작용하는 화학 물질을 개발하여 감염병을 치료하는 '화학요법'의 개념을 제시했습니다. 그의 연구는 최초의 합성 항생제인 살바르산 개발로 이어져 매독 치료에 획기적인 기여를 했습니다.
페니실린의 우연한 발견과 의학 혁명의 시작
항생제 시대의 본격적인 막을 올린 것은 알렉산더 플레밍의 페니실린 발견이었습니다. 1928년, 스코틀랜드의 세균학자였던 플레밍은 런던의 세인트 메리 병원에서 인플루엔자 바이러스를 연구하던 중 휴가를 마치고 돌아와 배양 접시를 확인했습니다. 실수로 포도상구균 배양 접시에 푸른 곰팡이가 자란 것을 발견한 그는 곰팡이 주변의 세균들이 자라지 못하고 녹아 있는 것을 관찰했습니다.
플레밍은 이 곰팡이가 세균의 성장을 억제하는 물질을 분비한다는 것을 알아내고, 곰팡이의 학명인 페니실리움(Penicillium)에서 이름을 따와 그 물질을 '페니실린'이라고 명명했습니다. 그는 페니실린이 다양한 세균에 효과가 있으며, 인체 세포에는 비교적 독성이 낮다는 사실을 확인했지만, 불안정한 성질 때문에 의약품으로 개발하는 데 어려움을 겪었습니다.
페니실린의 대량 생산과 항생제 시대의 개막
플레밍의 발견 이후 10년이 넘는 시간 동안 페니실린은 실험실 수준의 연구에 머물러 있었습니다. 하지만 1930년대 후반, 옥스퍼드 대학의 하워드 플로리와 에른스트 체인은 페니실린의 의학적 가능성에 주목하고 본격적인 연구에 착수했습니다. 이들은 끈질긴 노력 끝에 페니실린을 정제하고 동물 실험을 통해 효능과 안전성을 입증했습니다.
제2차 세계대전 발발은 페니실린 개발에 결정적인 전환점이 되었습니다. 전쟁 중 부상병들의 세균 감염 치료에 대한 필요성이 커지면서 미국과 영국 정부는 페니실린 대량 생산을 적극적으로 지원했습니다. 그 결과, 1940년대 중반부터 페니실린은 전 세계적으로 사용 가능한 의약품이 되었고, 수많은 생명을 구할 수 있었습니다.
플레밍, 플로리, 체인은 페니실린 개발의 공로를 인정받아 1945년 노벨 생리의학상을 공동 수상했습니다. 페니실린의 등장은 이전에는 치료가 어려웠던 폐렴, 패혈증, 뇌수막염 등의 세균 감염증을 효과적으로 치료할 수 있게 되면서 의학 역사에 새로운 장을 열었습니다. 이 시기를 '항생제의 황금기'라고 부르며, 스트렙토마이신, 테트라사이클린 등 다양한 종류의 항생제가 연이어 개발되었습니다.
항생제 내성이라는 새로운 위협
항생제의 광범위한 사용은 인류의 건강 증진에 엄청난 기여를 했지만, 동시에 '항생제 내성'이라는 새로운 위협을 불러왔습니다. 항생제에 노출된 세균 중 일부는 유전적인 변이를 통해 항생제에 대한 저항력을 갖게 되고, 이러한 내성균은 기존 항생제로는 치료가 어려워 심각한 감염병을 유발할 수 있습니다.
항생제 내성 문제는 전 세계적인 공중 보건 위협으로 부상하고 있으며, 새로운 항생제 개발의 필요성이 절실해지고 있습니다. 과학자들은 새로운 작용 기전을 가진 항생제 개발, 기존 항생제의 내성 극복 방안 연구, 항생제 오남용 방지 캠페인 등 다양한 노력을 기울이고 있습니다.
결론: 항생제의 빛과 그림자, 그리고 미래를 향한 노력
항생제의 역사는 인류가 감염병이라는 오랜 숙적에 맞서 싸워온 웅장한 기록입니다. 우연한 발견에서 시작된 페니실린은 수많은 생명을 구하며 의학의 혁명을 이끌었지만, 항생제 내성이라는 새로운 도전을 남기기도 했습니다. 우리는 항생제의 빛나는 업적을 기억하고, 동시에 그늘진 측면을 직시하며 미래 세대의 건강을 위해 지속적인 연구와 현명한 항생제 사용에 힘써야 할 것입니다.
'IT 에 관한 잡썰' 카테고리의 다른 글
| 날으는 공룡의 탄생: 익룡의 기원과 진화 (19) | 2025.04.10 |
|---|---|
| 미국은 왜 달에 원자폭탄을 터뜨리려 했나? 프로젝트 A119의 비밀 (55) | 2025.04.10 |
| 독서실의 역사, 현재, 그리고 미래: 공부 공간의 진화 (32) | 2025.04.08 |
| 이끼의 등장 역사와 의미: 작지만 위대한 녹색 생명체 (8) | 2025.04.08 |
| 사람 없는 공장? 현대차 울산공장에 로봇 5만 대 투입, 2025년의 미래 (38) | 2025.04.07 |